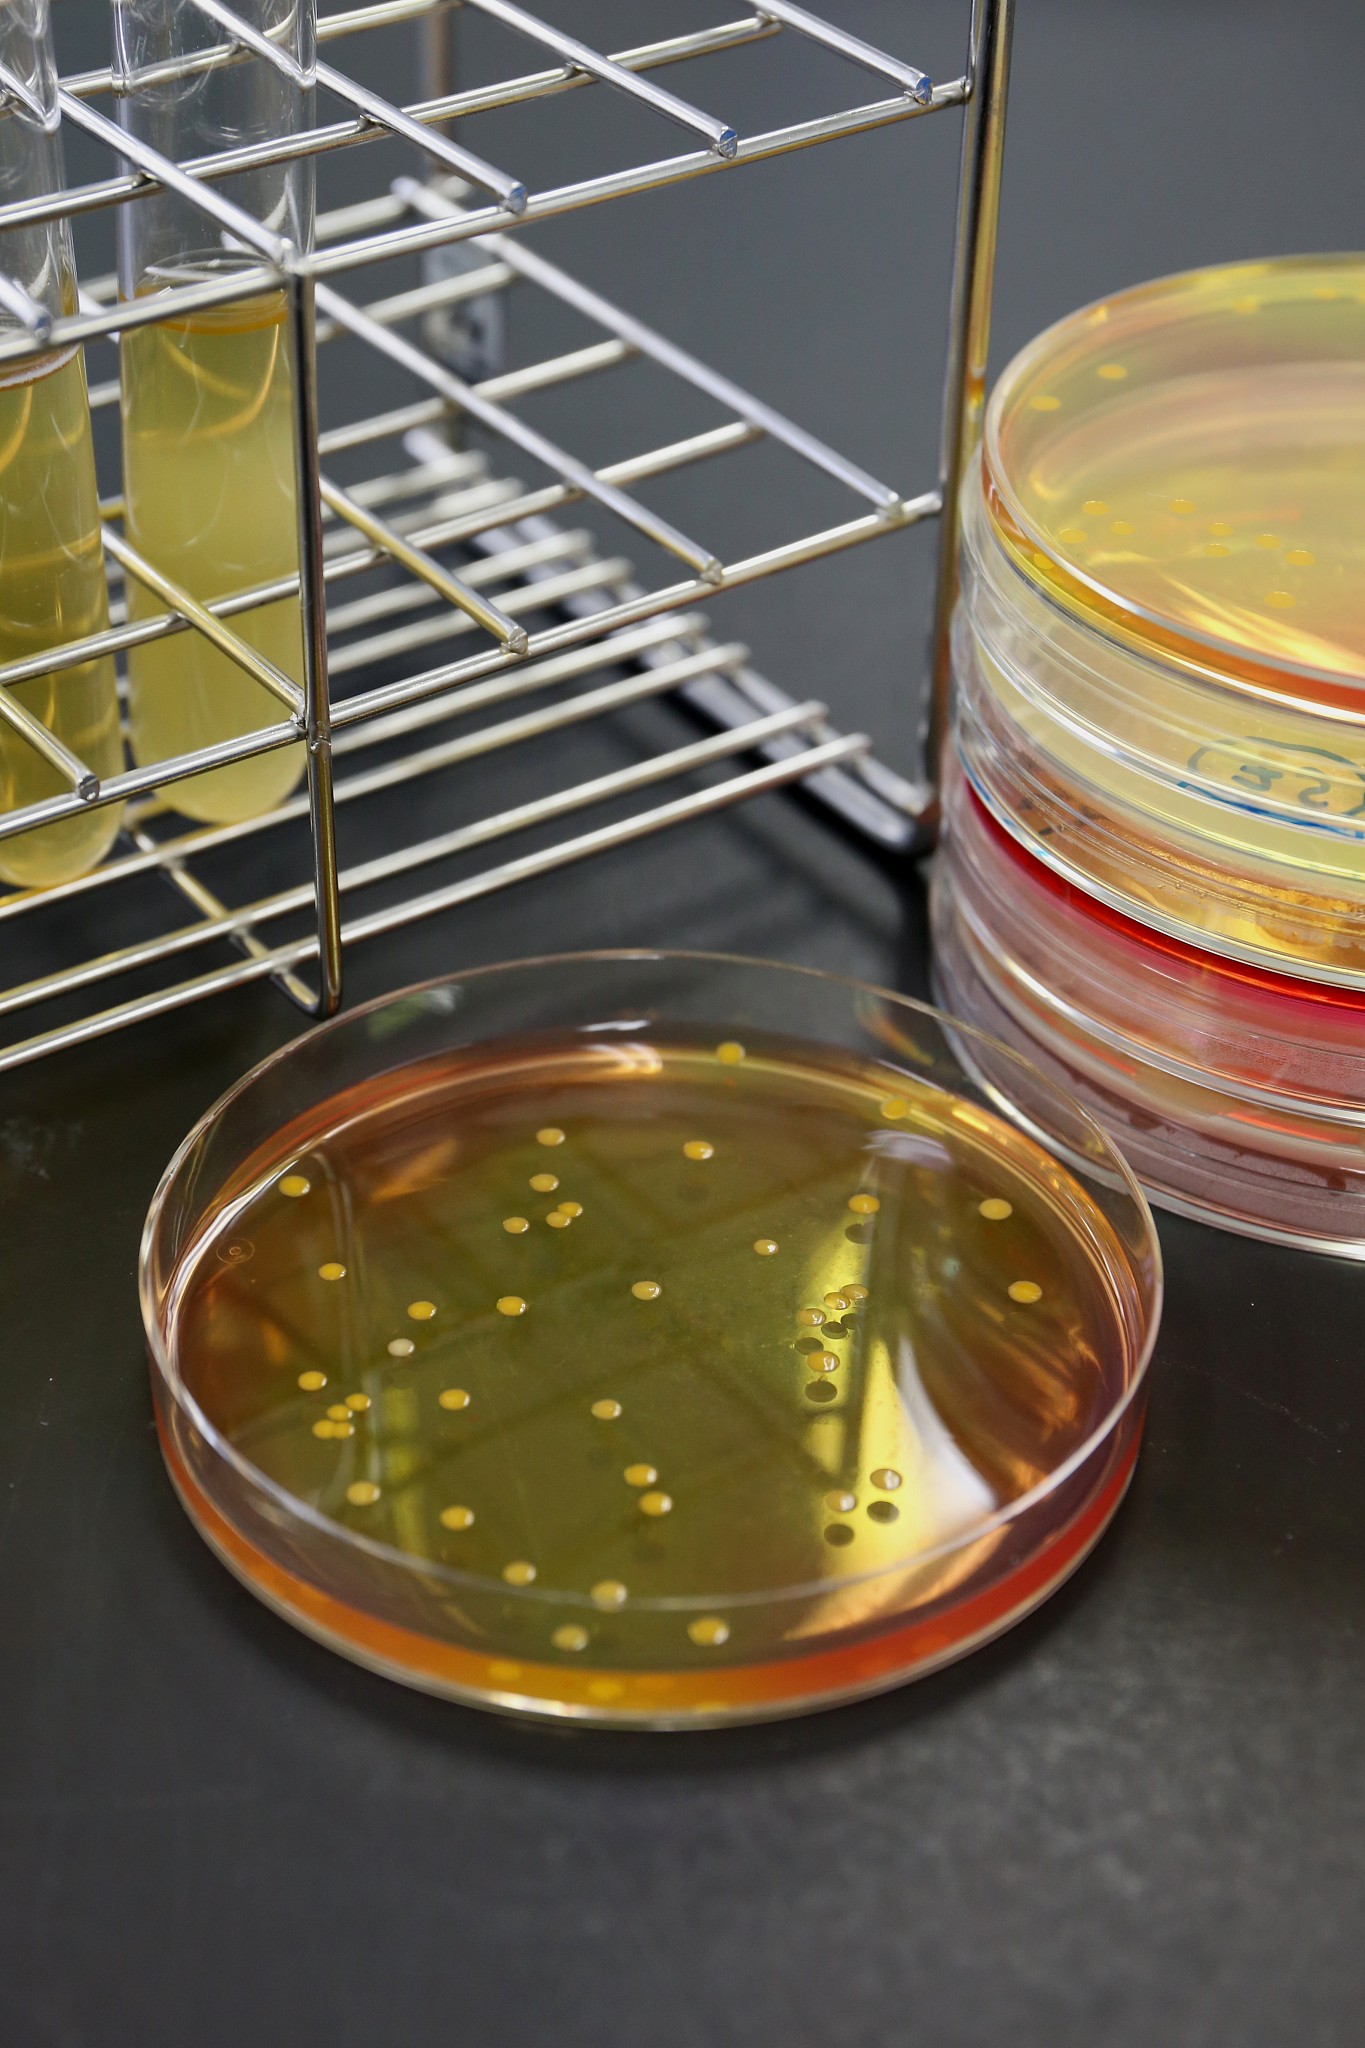
连续3篇日记关于小明和1个同学乱吃东西感染致泻性大肠杆菌一起在学校拉肚子两个人上课不断去厕所拉肚子一节课至少一次

连续3篇日记关于小明和1个同学乱吃东西感染致泻性大肠杆菌一起在学校拉肚子两个人上课不断去厕所拉肚子一节课至少一次
日记一:
日期:xx年xx月xx日 今天发生了一件非常糟糕的事情。上午的时候,我和我的好朋友小明一起在学校吃了一些不干净的东西,结果我们不知不觉中感染了致泻性大肠杆菌。午饭后,我们开始感到肚子不舒服,而且频繁地上厕所拉肚子。这真是太糟糕了,我们上课的时候都无法集中精力,因为每隔一段时间我们都要离开教室去厕所。这一节课,我和小明至少去了两次厕所,真是痛苦啊!希望我们能够尽快好起来。
日记二:
日期:xx年xx月xx日 今天是我们病倒的第二天了,但是情况并没有好转。我和小明还是不断地上厕所拉肚子。这让我们非常困扰,因为无论是在课堂上还是在课间休息,我们都无法正常地参与活动。老师看到我们的情况后,非常担心我们的健康状况,特别是因为我们都错过了很多重要的知识点。这让我感到非常沮丧,希望我们能够快点康复,不再受到这种困扰。
日记三:
日期:xx年xx月xx日 终于,我们渐渐康复了!今天我们上课的时候没有去厕所拉肚子,这让我感到非常开心。回顾过去的几天,我们真是吃了一堑,长了一智。我明白了饮食卫生的重要性,以后一定要注意食物的清洁和卫生。这次的经历不仅让我意识到了身体健康的重要性,还让我更加珍惜平时能够正常上课的时光。希望我们能够从这次的教训中吸取经验,以后不再犯同样的错误
原文地址: http://www.cveoy.top/t/topic/issC 著作权归作者所有。请勿转载和采集!